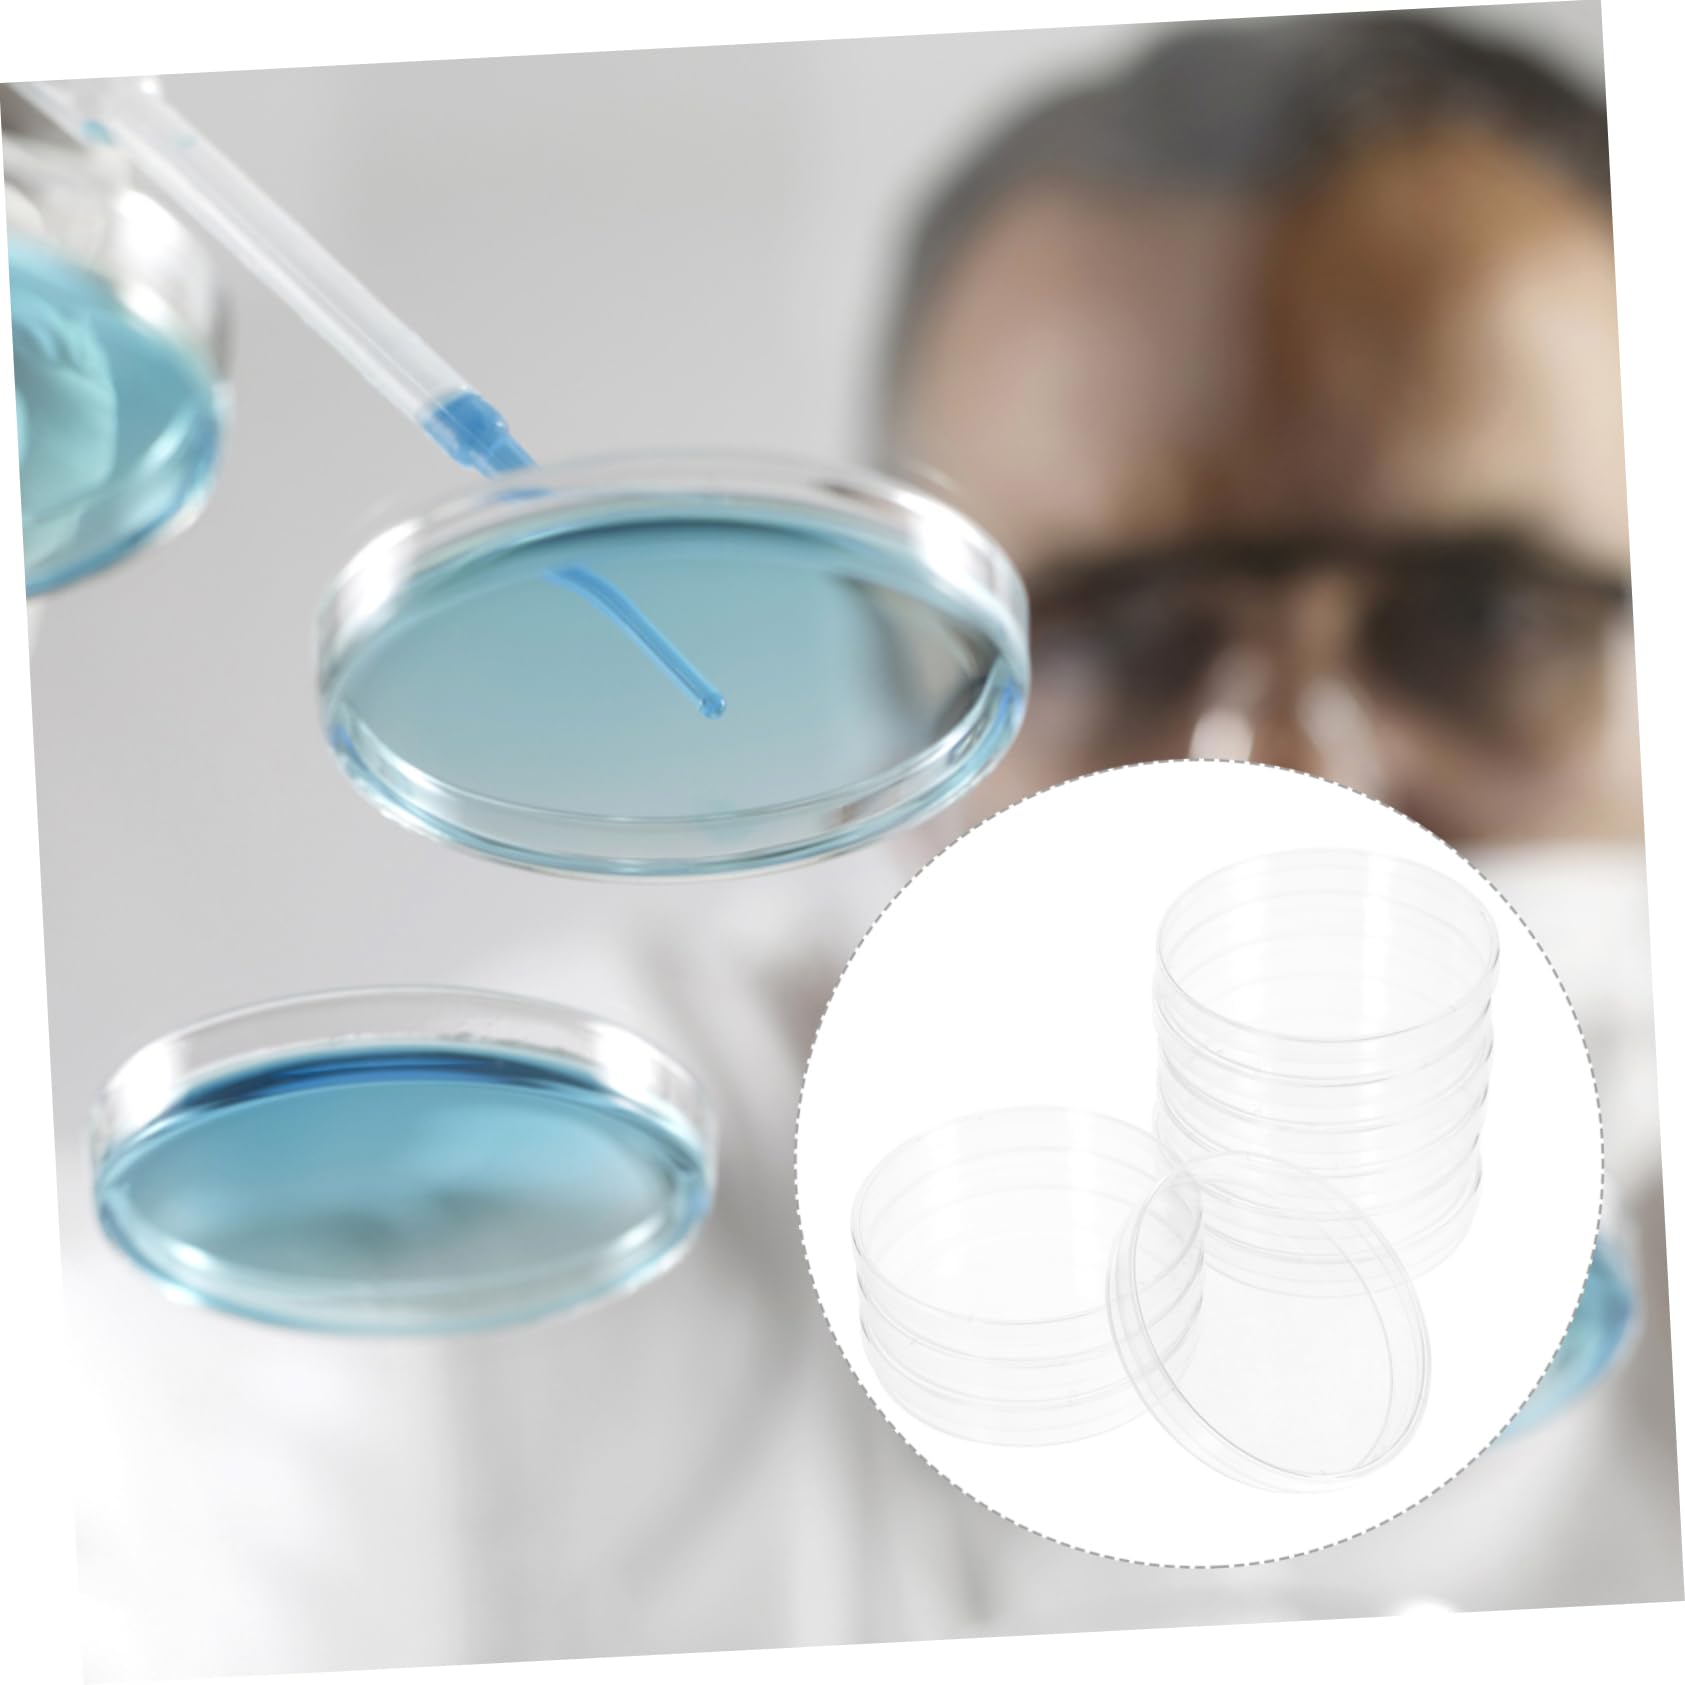
CIYODO 10pcs Square Petri Dish Tissue Culture Plate Agar Petri Dishes Lab Culture Holder Borosilicate Petri Dishes Cell Dish Laboratory Culture Holder Culture Dish Plastic Transparent

Product Information
Specification
Brand : CIYODO
BulletPoint1 : Culture dish: professional chemistry experimental tools, these culture dishes make experiment more successful,extract agar plates
BulletPoint2 : Agar dishes: simple structure, light weight, these culture holder are easy to be cleaned, give you a satisfying using experience,culture tray with lid
BulletPoint3 : Laboratory culture holder: manufactured with plastic materials, this clear culture dish will not easy to break,science supplies
BulletPoint4 : Culture plates: a culture dish for both scientific research and , teaching use, laboratory experiments, etc,culture plates with lid
BulletPoint5 : Lab culture holder: small size and light weight, these culture dishes can be taken easily anytime and anywhere,culture tray
Color : Transparent
ItemDisplayDimensions_Length : 3.54 centimeters
ItemDisplayWeight : 0.28 pounds
ItemName : CIYODO 10pcs Square Petri Dish Tissue Culture Plate Agar Petri Dishes Lab Culture Holder Borosilicate Petri Dishes Cell Dish Laboratory Culture Holder Culture Dish Plastic Transparent
ItemPackageDimensions_Height : 3.74 inches
ItemPackageDimensions_Length : 5.71 inches
ItemPackageDimensions_Width : 3.74 inches
ItemTypeKeyword : science-lab-petri-dishes
ItemVolume : 1 cubic_centimeters
Manufacturer : CIYODO
Material : Plastic
ModelNumber : 471HT45CH034TI6CO0HE
NumberOfItems : 1
NumberOfLithiumMetalCells : 1
PartNumber : 471HT45CH034TI6CO0HE
ProductDescription : Package List
10 x Culture Dishes with Lids
Features
-Material:Plastic cultrue
-Size:9.00X9.00X1.50cm/3.54X3.54X0 culture dish and lid.
-Color:Transparent coffee
- A culture dish for both scientific research and , teaching use, laboratory experiments, etc supplies.
- Disposable design, you can directly throw these culture dishes into the rubbish bin after used square.
- Transparent design, the culture dishes allow you to easily observe your samples inside and your efficiency petri.
- Simple structure, light weight, these culture holder are easy to be cleaned, give you a satisfying using experience culture tray round.
- Adopting plastic material, the culture dishes are very practical, will not easy to get deformed or broken square petri plates.
Goods Description
laboratory petri dish Our culture dishes are suitable for students to do experiments and also for scientific research.culture tray round for any home, school or laboratory use.tissue culture plate Widely used for education, chemistry, research, or life science .culture dish agar Enough quantity for you to use and replace
ProductSiteLaunchDate : 2024-10-04T20:36:58.269Z
Size : 9X9cm
SupplierDeclaredDgHzRegulation : not_applicable
UnitCount : 1
UnspscCode : 41000000